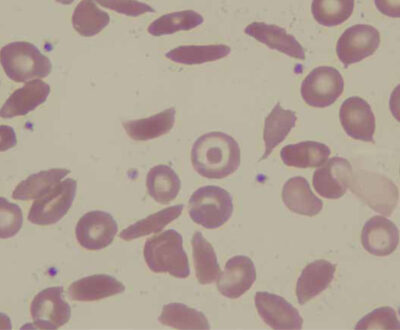
Multiple sickle cells in a blood smear

Haematological conditions are common in daily practice of tropical medicine; many patients present with some degree of anaemia, by far the most common haematological problem. Anaemia is always the result of an underlying condition, infections such as malaria being the most common, especially among children. In addition, many otherwise ‘healthy’ people have haemoglobin levels below what is considered normal. Iron supplementation is one of the most commonly prescribed therapies to correct iron deficiency related anaemia; it is cheap, widely available and usually well tolerated. However, iron supplementation has been the subject...
Haematological conditions are common in daily practice of tropical medicine; many patients present with some degree of anaemia, by far the most common haematological problem. Anaemia is always the result of an underlying condition, infections such as malaria being the most common, especially among children. In addition, many otherwise ‘healthy’ people have haemoglobin levels below what is considered normal. Iron supplementation is one of the most commonly prescribed therapies to correct iron deficiency related anaemia; it is cheap, widely available and usually well tolerated. However, iron supplementation has been the subject of debate. The increased susceptibility, particularly for malaria, may require a more comprehensive approach including malaria control. In the past, sickle cell disease was typically restricted to the tropics, but nowadays it is spread worldwide. The disease arrived in the Americas and in the Caribbean during the slave trade and more recently in other regions via migration. It is a strange twist that patients may have severe morbidity, whereas carriers contribute to the persistence of the mutation due to the partial immunity it provides to malaria. In the Netherlands, the number of patients with sickle cell disease has increased in recent years. Over time, care has improved considerably with seven specialized centres collaborating in a multidisciplinary team including clinicians, geneticists, social workers and psychologists. A comprehensive approach has been developed that includes active follow-up, neonatal screening and research. Hopefully, this model can be introduced to LMICs, where treatment is often symptomatic, including repeated blood transfusions. Another common clinical problem that puts a drain on blood transfusion resources is pancytopenia, a neglected clinical entity in which red cell, white cell and platelet production is reduced causing anaemia, infections and bleeding complications. It is difficult to manage in LMICs, as diagnostic capacity is often limited and the underlying cause is therefore not treated. As a result, multiple repeated blood transfusions are given with associated risks. Safe blood transfusion is therefore among the greatest needs in many LMICs. The Malawi Blood Transfusion Service (MBTS) was established 14 years ago. Public beliefs around blood donation, identifying voluntary blood donors, screening for infections, outreach to communities, and funding are among the challenges the MBTS faces. Nevertheless much has been achieved. Many of us who worked in the tropics will have experienced problems of non-availability of blood or screening tests, such as for HIV, resulting in the horror scenario of transfusing unscreened blood. Similarly, great advances have been made in relation to childhood malignancies, of which Burkitt lymphoma is the most common. Close collaboration between Malawi and the Netherlands proved very successful. One lesson learned is the importance of an adapted approach to management in LMICs, including research for better treatment. As a result of work done in recent years, cure rates have improved considerably. Haematology has gained a firm place in the scientific literature. Successful collaboration and research has led to improved understanding and management of common conditions. The articles in this edition clearly show the interrelationship between various haematological conditions and their management (e.g. malaria, anaemia, iron supplementation), including the need for safe blood. They also discuss the specific needs of LMICs, both in clinical medicine and public health.
Ed Zijlstra
Josephine van de Maat
Jan Auke Dijkstra